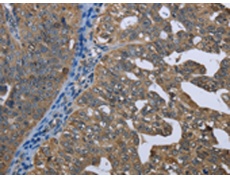
一抗

|
Background: |
This gene encodes a mitochondrial enzyme which prefers saturated fatty acids as its substrate for the synthesis of glycerolipids. This metabolic pathway's first step is catalyzed by the encoded enzyme. Two forms for this enzyme exist, one in the mitochondria and one in the endoplasmic reticulum. Two alternatively spliced transcript variants have been described for this gene. |
|
Applications: |
ELISA, IHC |
|
Name of antibody: |
GPAM |
|
Immunogen: |
Fusion protein of human GPAM |
|
Full name: |
glycerol-3-phosphate acyltransferase, mitochondrial |
|
Synonyms: |
GPAT; GPAT1 |
|
SwissProt: |
Q9HCL2 |
|
ELISA Recommended dilution: |
2000-10000 |
|
IHC positive control: |
Human ovarian cancer and human gastric cancer |
|
IHC Recommend dilution: |
100-300 |

 購物車
購物車 幫助
幫助
 021-54845833/15800441009
021-54845833/15800441009